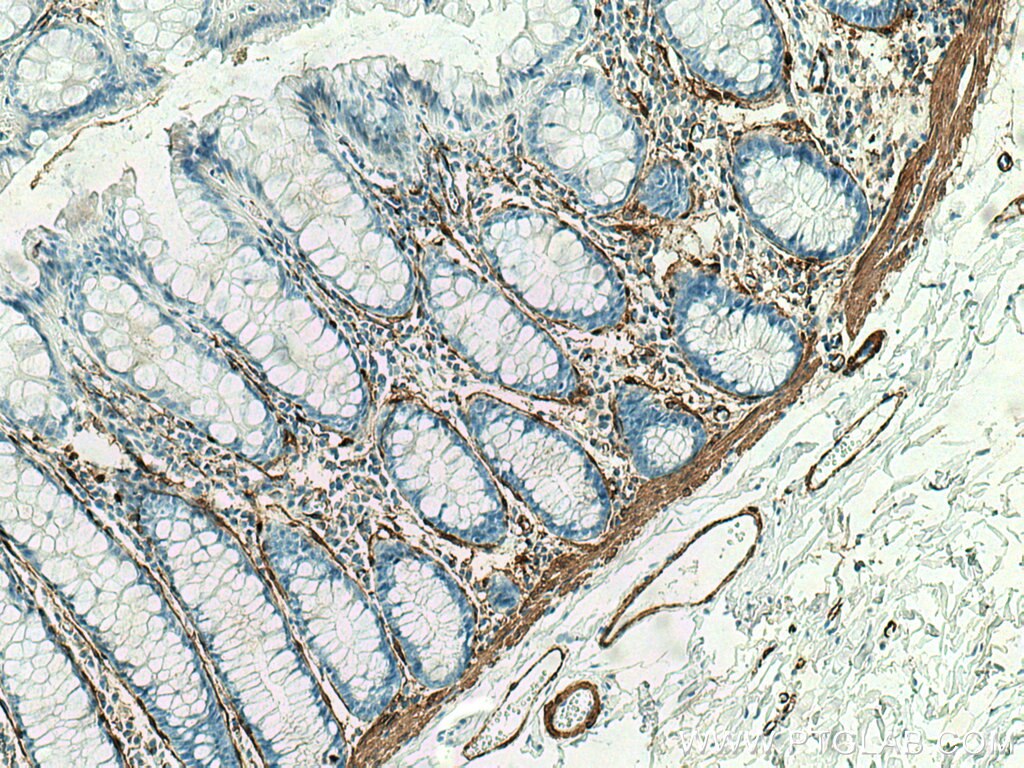

Filters
New chat
Able™
正在加载,请稍候...